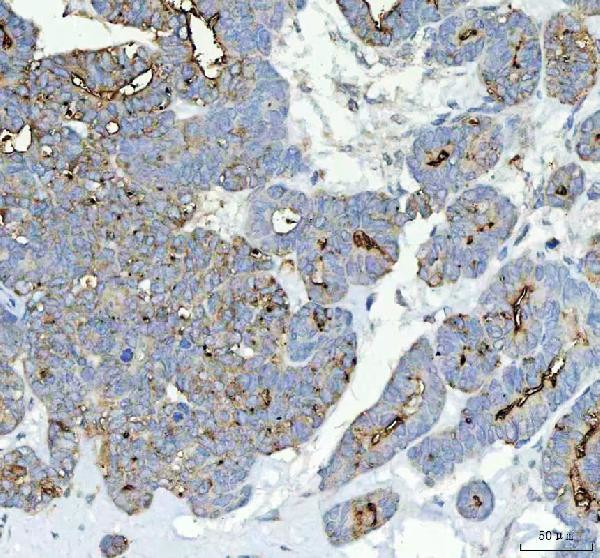
ALPL Antibody in Immunohistochemistry (Paraffin) (IHC (P))

Search
Invitrogen
ALPL Polyclonal Antibody
{{$productOrderCtrl.translations['antibody.pdp.commerceCard.promotion.promotions']}}
{{$productOrderCtrl.translations['antibody.pdp.commerceCard.promotion.viewpromo']}}
{{$productOrderCtrl.translations['antibody.pdp.commerceCard.promotion.promocode']}}: {{promo.promoCode}} {{promo.promoTitle}} {{promo.promoDescription}}. {{$productOrderCtrl.translations['antibody.pdp.commerceCard.promotion.learnmore']}}
图: 1 / 2
ALPL Antibody (PA5-78763) in IHC (P)


产品信息
PA5-78763
种属反应
宿主/亚型
分类
类型
抗原
偶联物
形式
浓度
规格
纯化类型
保存液
内含物
保存条件
运输条件
RRID
产品详细信息
Reconstitute with 0.2 mL of distilled water to yield a concentration of 500 µg/mL.
Positive Control - WB: human Hela whole cell, human 293T whole cell. IHC: human parotid acinar cell carcinoma tissue.
靶标信息
Alkaline phosphatase is a homodimeric protein enzyme (86 kDa), containing two zinc atoms crucial to its catalytic function per monomer, and it is optimally active at alkaline pH environments. The enzyme is found in prokaryotes and eukaryotes, with the same general function but in different structural forms suitable to organism's environment. ALP plays a role in liver metabolism and development within the skeleton. In bacteria, ALP acts as a source of inorganic phosphate. In yeast, ALP can be a useful protein for studying membrane protein sorting.
仅用于科研。不用于诊断过程。未经明确授权不得转售。
篇参考文献 (0)
生物信息学
蛋白别名: Alkaline phosphatase liver/bone/kidney isozyme; alkaline phosphatase, liver/bone/kidney; Alkaline phosphatase, tissue-nonspecific isozyme; AP-TNAP; FLJ40094; FLJ93059; glycerophosphatase; liver/bone/kidney-type alkaline phosphatase; MGC161443; MGC167935; Phosphoamidase; Phosphocreatine phosphatase; tissue non-specific alkaline phosphatase; tissue-nonspecific ALP; unnamed protein product
基因别名: ALPL; AP-TNAP; APTNAP; HOPS; HPPA; HPPC; HPPI; HPPO; TNALP; TNAP; TNS-ALP; TNSALP
UniProt ID: (Human) P05186
Entrez Gene ID: (Human) 249